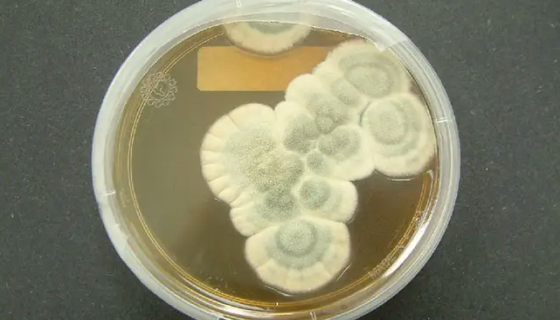
产黄青霉的主要用途与实验内容及保藏方法！
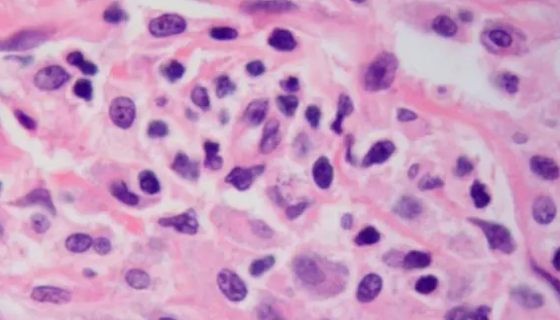
LAD2人肥大细胞收到后的处理方法与培养步骤！

产黄青霉的主要用途与实验内容及保藏方法!
产黄青霉属无性型真菌,一种属于半知菌亚门丝孢纲丝孢目(从梗孢...

ATCC 32609 格特隐球菌——用于生物医学研究
格特隐球菌主要分布于热带和亚热带夏季湿热的地区,如澳大利亚北...

CT26小鼠结肠细胞的培养操作规程及注意事项!
小鼠结肠癌细胞是被N-亚硝基-N-甲基脲烷(NNMU)诱导得...

Biobw产品助力 影响因子 5.581
Biobw产品助力 影响因子 5.581

ATCC 23745 脆弱类拟杆菌 百欧博伟生物
脆弱拟杆菌(b.fragilis) 是临床上最常见的一种厌氧...
LAD2人肥大细胞收到后的处理方法与培养步骤!
人肥大细胞,仅用于科学研究或者工业应用等非医疗目的不可用于人...

产气肠杆菌——实验室试剂用水检测标准菌
产气肠杆菌主要生存于人类和动物的肠道,为人体内的正常菌群,只...

小鼠牙乳突细胞的复苏与传代及冻存操作说明!
小鼠牙乳突细胞MDPC-23取自CD-1小鼠,仅用于科学研究...